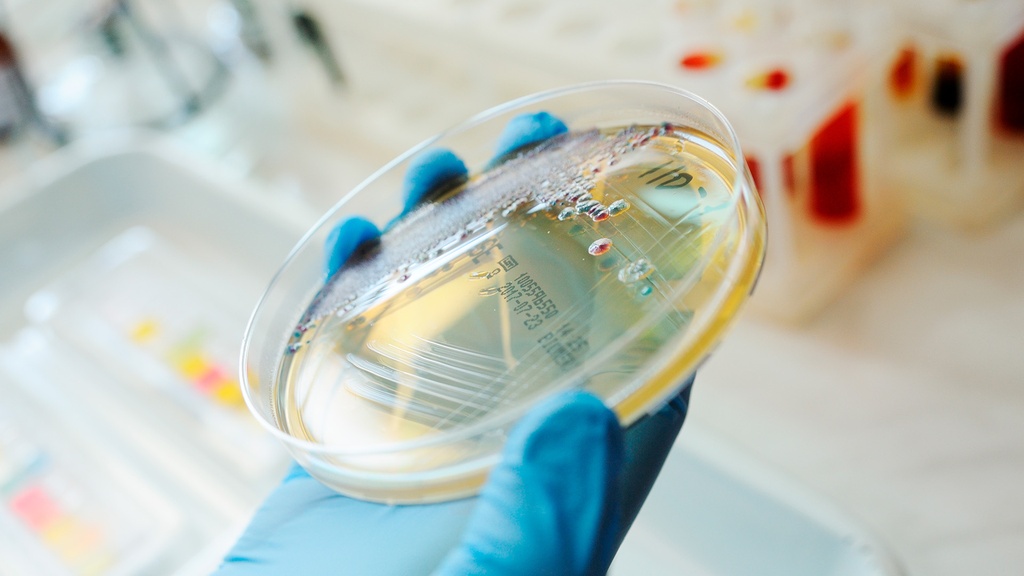
Coprológico

Coprológico
1- Recolectar en un frasco limpio una muestra de materia fecal del tamaño de una nuez (5 g)
2- Etiquetarla con fecha y nombre completo.
3- Entregar al Laboratorio lo antes posible sin tener más de 2 hrs de haber sido emitida.
4- No ingerir betabel, carnes rojas, brócoli, melón, nabo y rábano, al menos dos días antes de la recolección de la muestra.
Tiempo de Entrega: 1 día hábil
Mediante este estudio de las heces bajo microscopio principalmente se buscan micro organismos frecuentes que causan algunas enfermedades del tracto gastrointestinal, principalmente de origen parasitario y/o infeccioso. Al igual que se pueden observar características anómalas de las heces como sangre.
Análisis de heces
Recolectar en un frasco limpio una muestra de materia fecal del tamaño de una nuez (5 gr), etiquetarla con nombre completo y que no tenga más de 2 horas de haber sido emitida. El frasco se puede conseguir en cualqueir farmacia
Entregar al flebotomista al momento de su llegada
Mediante este estudio se puede detectas la presencia de diferentes microorganismos o sustancias que no deberían estar dentro de los desechos de una persona saludable y podría ayudarle a tu médico a combatir diferentes padecimientos.
NO